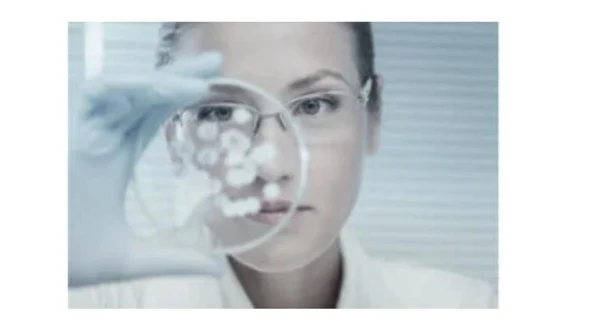
image-2

Профессиональный, опытный косметик-эстетист
Холодная плазма-инвестиция в вашу уверенность, красоту и долголетие! Позвольте себе сиять и восхищать окружающих своей молодостью и красотой!
Холодная плазма-инновационная процедура, словно волшебная палочка, способна преобразить кожу, вернуть ей упругость, эластичность и здоровый цвет. Она подходит для любого возраста и типа кожи, решая широкий спектр проблем - от морщин и пигментации до акне и рубцов.
ПЛАЗМЕННОЕ ОМОЛОЖЕНИЕ это: - неинвазивно, а значит нетравматично и безопасно - эффект от процедуры нарастающий (самый ярко выраженный эффект наступает через 2 месяца) - процедура эффективна и очень доступна -не оставляет шрамов и рубцов, без побочных эффектов - подтягивает кожу за счет выработки собственного коллагена и эластина - подходит для любых зон. Холодная плазма предоставляет возможность поддерживать молодость и здоровья кожи.









| Лицо ................................................4000 руб |
| Лицо+веки......................................5000 руб |
| Веки верхние..................................2000 руб |
| Веки нижние...................................2000 руб |
| Шея ...................................................2000 руб |
| Декольте...........................................2000 руб |
| Грудь.............................................от 2000 руб |
| Живот................................................5000 руб |
| Бока....................................................6000 руб |
| Живот+бока......................................8000 руб |
| Бедра..................................................6000 руб |
| Папилломы, шипицы.................от 300 руб |
| Гипергидроз подмышек (повышенная потливость)........................................2000 руб |
| Гипергидроз стоп (повышенная потливость)........................................2000 руб |
| Кисти рук.............................................2000 руб |
| Акне, постакне...............................от 2000 руб |
| Растяжки, стрии............................от 1000 руб |
| Стимуляция роста волос, загущение, аллопеция, дерматит........................3000 руб |
| Интимное омоложение....................6000 руб |
| Холка (вдовий горбик).................от 2000 руб |

Мы находимся по адресу: г. Кемерово, пр-кт. Ленинградский, д. 47, салон "Вива"

Что такое холодная плазма? Это особая форма веществ, состоящая из заряженных частиц и нейтральных молекул, обладающая уникальной способностью глубоко проникать в кожу, стимулируя регенерацию клеток и выработку коллагена. Главное преимущество - температура воздействия настолько низкая, что процедура комфортна и практически безболезненна.